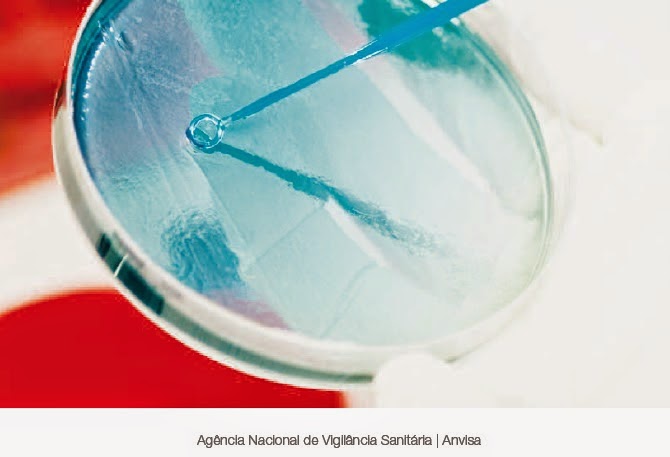

Livro Saude Total Pdf Download Gratis
derrkayl
Download: https://byltly.com/297zt0
app para baixar livro saude total gratuitos. livro saude total pdf baixar gratis a9c2e16639
Related:
Cactus-A Story Of Hope movie download utorrent free
Chiavi Di Attivazione Pinnacle Studio 11 Plus Serial Numberrar
Galitsin 151 Paradise Rain Alice